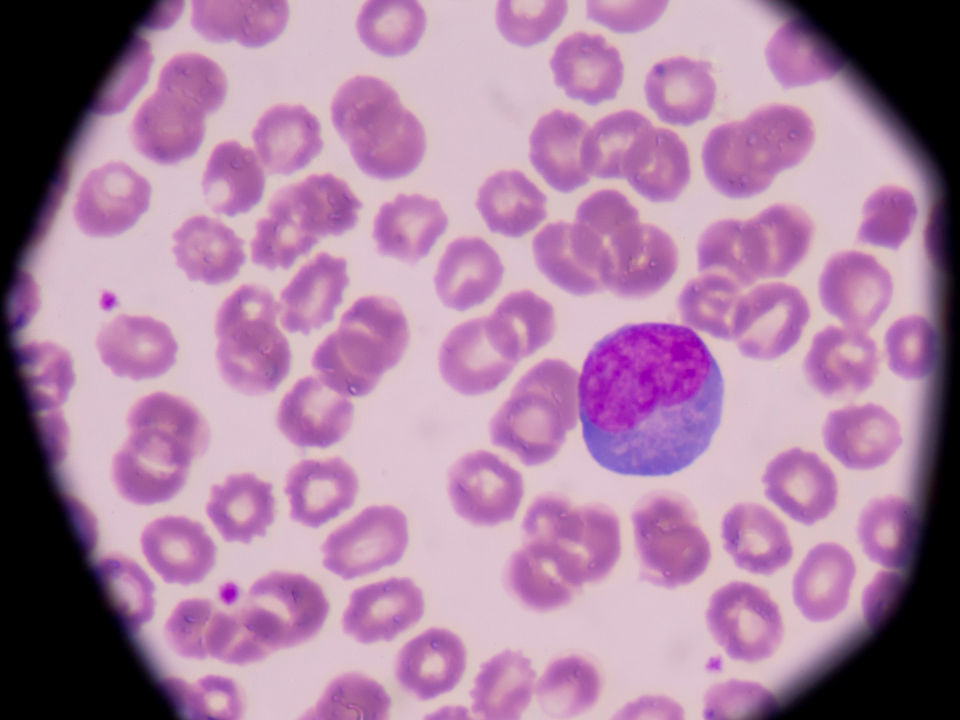
Linfócitos anormais ou anômalos

As células linfomatosas circulantes são comuns em linfomas não Hodgkin que se apresentam na fase leucêmica e cujo linfócitos anormais ou anômalos podem ser encontrados no sangue periférico. Estas células clonais apresentam alterações morfológicas nucleares e, classicamente apresentam monotonia celular (repetição dos achados morfológicos). O termo linfócito anormal está associado a neoplasias, e devem ser contados de forma distinta da contagem diferencial, com descrição morfológica nos comentários ou observações.
Existem pelo menos 10 tipos de linfomas que apresentam na fase leucêmica e que podem ser identificados através do exame de sangue periférico. Dentre estes destacam-se o linfoma do Manto, o linfoma folicular, linfoma esplênico da zona marginal, linfoma de Burkitt, linfoma difuso de grandes células B, linfoma linfoplasmocítico, linfoma linfoplasmoblástico, leucemia/linfoma de célula T, Síndrome de Sézary. No linfoma do manto as células apresentam endentações nucleares, no linfoma folicular os linfócitos apresentam núcleo clivado, no linfoma esplênico da zona marginal nas células exibem projeções citoplasmáticas polares, já o linfoma de Burkitt são encontrados no sangue periférico células grandes com vacúolos citoplasmáticos e nucleares. Os linfomas T periféricos são mais agressivos e incuráveis e a morfologia pode auxiliar no diagnóstico, como em casos de hemogramas de pacientes com Síndrome de Sézary, na qual os linfócitos possuem o núcleo convoluto ou cerebriforme, e na leucemia/linfoma de células T associada ao HTLV, os linfócitos anormais possuem núcleo em forma de trevo de 4 folhas ou em forma de flor.
Vale destacar que o relato da presença de células linfóides anômalos deve ser realizado com cautela, e quando se encontra no exame do sangue periférico uma célula anormal, procure outras, verifique se há linfocitose, e relate em percentagem estas células. Como o uso desta nomenclatura mostra o valor limitado da morfologia nas neoplasias hematológicas e o diagnóstico é feito por meio da imunofenotipagem. Na suspeita de linfomas periféricos com linfócitos anômalos circulantes, sempre consulte um atlas para ter mais segurança na identificação dos linfócitos anômalos, e entre contato com o médico hematologista, certificando se o paciente possui diagnóstico.
Dr. Luiz Arthur Calheiros Leite
Consultor em Hematologia, Doutor em Bioquímica, UFPE, Mestre e Especialista em Hematologia, UNIFESP. Contato – Instagram: @drluizarthur
Referências:
– RECOMENDAÇÕES DO ICSH PARA A PADRONIZAÇÃO DA NOMENCLATURA E DA GRADUAÇÃO DAS ALTERAÇÕES MORFOLÓGICAS NO SANGUE PERIFÉRICO. (Tradução e adaptação do Dr. Marcos Kneip Fleury – Assessor Científico do PNCQ em Hematologia)
– ICSH recommendations for the standardization of nomenclature and grading of peripheral blood cell morphological features. Palmer L, Briggs C, McFadden S, Zini G, Burthem J, Rozenberg G, Proytcheva M, Machin SJ. Int J Lab Hematol. 2015 Jun;37(3):287-303